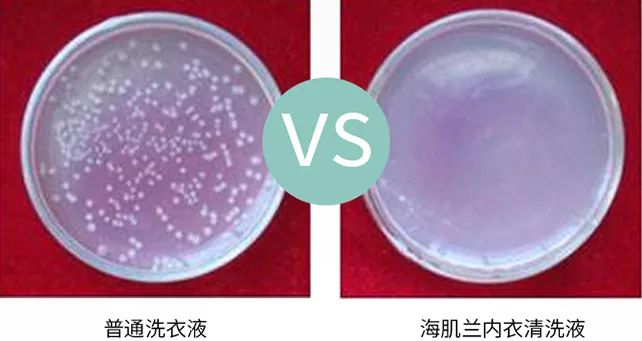

许多人表面上光鲜亮丽
实际上个人卫生都没弄干净
精致猪猪女孩不能只做表面功夫
私处卫生一定不能忽视

否则尴尬的瘙痒,异味一定找上门来
世界卫生组织更是表明
女性85%的妇科病
都源于内裤不干净

据微生物学者研究发现
一条脏的内裤上带有0.1克粪便
而1克粪便中含有100万个细菌
1000个寄生虫包囊和100个虫卵!


内衣裤的清洗是个技术活
不能和其他衣物扔进洗衣机
会造成交叉二次感染


反复搓洗不净 发黄发硬
普通的肥皂,清洗剂
根本就洗不干净,而且太多
化学物质会刺激私处,有残留
十有八九引起健康问题

所以女性朋友们一定要谨慎挑选
私处衣物的清洁剂啊!!!
今天小编真的强烈推荐给你们这款
澳洲专业护理品牌——
NACUQINGFIT海肌兰内衣清洗液

银离子+生物酶+氨基酸
深沉分解血迹,白带分泌物
茶花清香去异味,易漂易洗
温和到孕妇孩子都可以使用
1
澳洲护理品牌
畅销52年的口腔护理专家
海肌兰是一个护理品牌
创立于1968年
隶属澳大利亚柏丝琳控股集团
追求“自然、安全、健康”的理念


拥有全球顶级有机植物原料提取技术成果
更是天然个人护理品的倡导者和领导者

澳洲品牌原装进口
报关单一目了然,值得信赖!

而且在小红薯上深受用户各种好评
大家都被它出色的清洁力而折服
炒鸡温和亲肤



2
世界首款复合型靶向蛋白酶
超强去污去渍,省心又省力
女性朋友们都深有体会
总有那么几天小麻烦
生理期间偶尔弄脏内裤
如果不及时清洗掉
普通的洗衣液根本
是洗不掉干掉的血迹的

但是靠它就可以
因为它添加了特殊的“复合型蛋白酶”

这是由英国禾大研发的
世界首款复合型靶向蛋白酶

简单的说:我们内衣上的分泌物
主要是蛋白质,这种蛋白酶就是专门
用来清理蛋白质构成的污渍

这种复合蛋白酶就是血渍的“克星”
拿它和其他品牌的内衣清洗剂做了对比
效果怎样一目了然!

看,和其他的内衣清洗剂对比
分解力真的高出了很多
海肌兰清洗剂能自然溶解去渍
不需大力揉搓也能达到高效去污

为了更直观看到它的溶解力
我们用蛋白液模拟身体分泌的液体
分别倒在普通洗衣液和海肌兰洗衣液中

静放10分钟之后可以明显看到
普通洗衣液还是之前的样子
而海肌兰洗衣液中的蛋白被酶分解了

而且这种蛋白酶像是
自带保护衣一样,遇水不会即化
当接触编织物或纤维后
外壳破裂释放蛋白酶
高效渗透进内衣裤的每一个缝隙
不放过任何一个死角


因此在清洗的时候
先浸泡10分钟左右用
再轻轻搓揉几下
之前难洗的血渍等就被洗的干干净净



平时那些边缘有黄色汗渍洗不干净的地方
用海肌兰内衣洗泡一泡搓一搓都没有了

它的高清洁力不止于此
就连女生平时的口红污渍
衣服上不小心粘上的油渍
浸泡之后稍加搓洗都能干干净净



3
医用级银离子安全消毒成分
除菌率高达99%

更值得一提的还有成分里来自瑞士科莱的
医用级银离子安全消毒成分

0.6%的银离子能去除
看不见的细菌、病毒
从根本上预防妇科疾病
对白色念珠菌、金黄色葡萄球菌、大肠杆菌
等具有高达99%以上的杀菌效果

也就是说这款清洁剂不仅是
可以把内衣洗的很干净,还能够抑菌
通过专业的机构检测
除菌率高达99%


通过实验可以看到加入洗衣液后
菌群就没有了活动的迹象


银离子慢慢释放的过程还能
长效抑制细菌的滋生和繁殖
而且它能深入的杀菌
就连文胸里的棉杯也能清洗干净
真的比普通洗衣液好用太多了
洗出来就像新的一样


4
温和呵护私处健康
不伤衣物不伤手
清洗液非常清澈
一打开倒出来就能闻到
超好闻的“茶树清香味”~

透明水漾质地
加水马上就能起泡


泡沫十分易漂洗
用水冲洗几遍就可以
完全不会假滑和残留

成分温和安全
不添加荧光增白剂、磺酸、磷、酚、苯
等有害物质,漂洗完之后也无残留
成分里的添加的月桂酰肌胺酸纳
俗称小分子氨基酸)
起到了稳定酸碱,护衣又护手的作用

经过测试酸碱值在5.5---6左右
和人体自身酸碱值非常贴近
对皮肤是比较友好的

除了能维护私处的酸碱平衡
洗完的衣服不会发黄发硬
不像市面上有些洗涤产品含有工业碱
容易破坏衣物纤维,导致衣物发黄发旧
还会伤手,伤皮肤

洗完衣物柔软细腻,非常贴身
不会发硬干枯,上身舒适感太赞了

家里的羊毛衫,真丝裙
蕾丝内衣裤,奢侈品围巾
用它洗也是完全ok的

家里的孕妇衣物
婴儿,儿童衣物有了它
不用再买专门的洗剂


4
一瓶盖能洗4件内衣
耐用划算
这款内衣洗的细节设计也非常的贴心
它的瓶嘴采用的是拉环式的设计
可以隔绝细菌污染到瓶内的液体

△拉出拉环后无需再重复堵住出液口
它的瓶盖起到了量杯的作用
比起那种按压式设计更容易控制用量
每次仅需一小瓶盖,就能打出绵密的泡沫
一次倒出的量约5ml
可以清洗3~4件内衣

一大瓶足足有550ml,十分耐用
现在购买还赠送80ML的旅行装
性价比超高
只需要¥29.9元

很多女性朋友在经历过
妇科疾病的烦恼之后
非常重视私处贴身衣物的清洁
最终选择了这款,并且认定不再更换
想要提升健康幸福感,值得入手

只要¥29.9元
1:1赠送80ml旅行装
第二瓶还立减5元
点击抢购